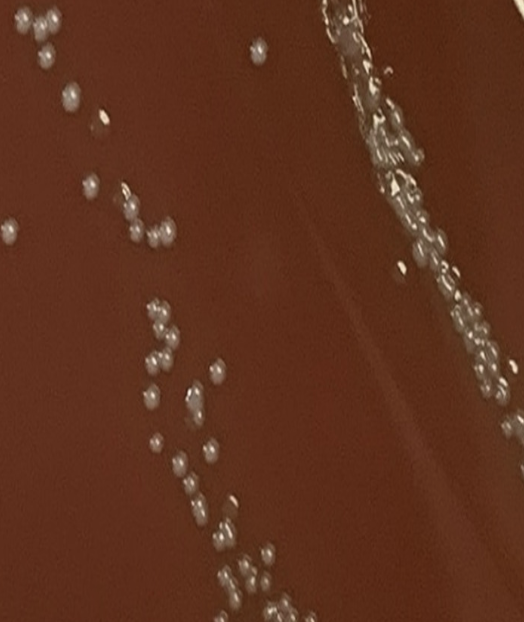
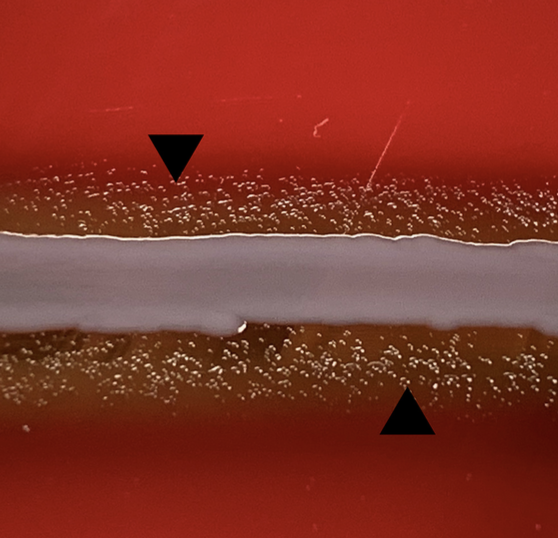

Indiana University Infectious Diseases Fellowship
10 Nov,
5 tweets, 4 min read
#idboardreview A pt w/ fever & night sweats x3wk, +5lb wt loss, +systolic ejection murmur. BC+ GPC subculture growth on chocolate agar. dx? #meded #idmedEd #idtwitter

Infective endocarditis due to nutritionally variant streptococcus #Abiotrophia defectiva
Q Ref GWIDBR pics Ref: journals.asm.org/doi/10.1128/JC…
Q Ref GWIDBR pics Ref: journals.asm.org/doi/10.1128/JC…
#Abiotrophia grows as satellite colonies around supporting microorganisms such as around a staphylococcal streak
• • •
Missing some Tweet in this thread? You can try to
force a refresh













